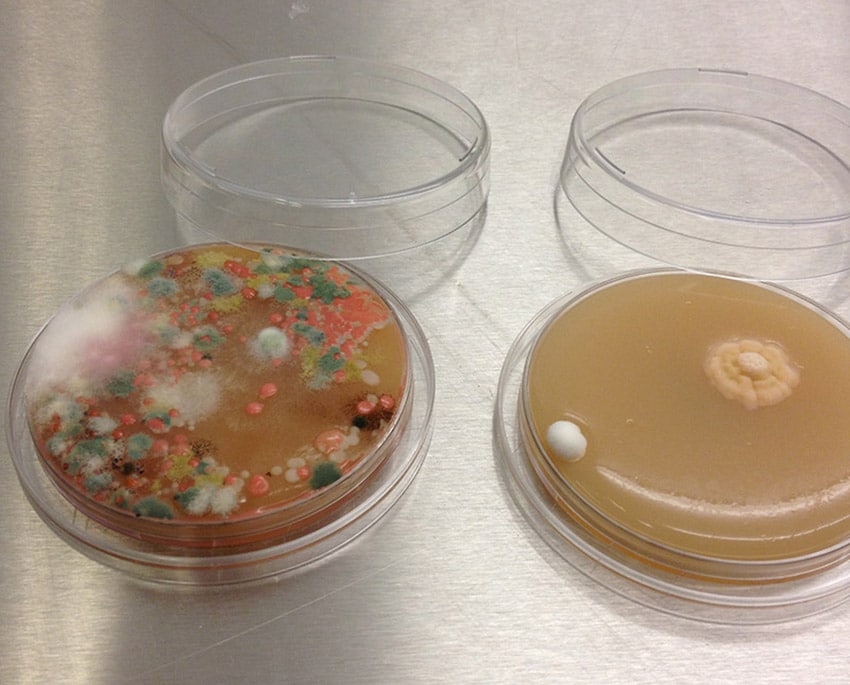
Det finns bland annat möjlighet att testa mögel genom en avtrycksplatta, du kan mäta mögel i luften med vårt lufttest

Förekommer ofta
Några sorter som förekommer ofta är Stachybotrys, Aspergillus, Penicillium, Fusarium och Cladosporium.
Penicillium: Penicillum är en släkt av mögel som innehåller över 300 olika arter. Mögelt finns i alla olika miljöer inklusive mark, luft, vatten och organiskt material. Penicillium kan producera en mängd olika naturliga produkter, inklusive antibiotika, enzymer och andra kemikalier.
Penicillin var den första antibiotikan som upptäcktes. Upptäckten av penicillin anses vara en av de största medicinska genombrottet i modern historia och har räddat miljontals liv.
Penicillium är också viktigt i livsmedelsindustrin då vissa arter används för att producera ost, inklusive blåmögelost och Camembert. Penicillium kan också används för att producera andra produkter som skinka och salami.
Även om mögelet kan vara användbart för människan, kan det också vara ett stort problem då vissa arter av möglet kan orsaka allvarliga allergiska reaktioner och sjukdomar hos människor och djur. Penicillum kan också orsaka stora skador på byggnader.
Stachybotrys: Stachybotrys är en typ av mögelsvamp som ofta dyker upp i byggnader med fuktskador samt låg ventilation. Exponering till stachybotrys kan orsaka en rad hälsoproblem, inklusive huvudvärk, trötthet, irritation i ögon, näsa och hals, andningsbesvär och andra allergi liknande symtomer. I allvarliga fall kan exponering till stachybotrys orsaka allvarliga hälsoproblem bland vuxna såsom neurologiska problem. Samma hälsoprblem kan uppstå hos barn. Barn kan även få symptomer som utvecklingsstörningar och läkemedelsresistens.
Det är viktigt att förebygga fuktskador i byggnader och att regelbundet undersöka för förekomst av stachybotrys för att minimera människors exponering. Om stachybotrys upptäcks är det viktigt att arbeta med professionella sanerare för att säkerställa säker och effektiv eleminering av svampen.
Aspergillus: Aspergillus är en stor släkt av mögelsvamp som finns ute i naturen över hela världen. Det finns mer än 200 olika arter av, varav många orsaka sjukdomar hos människor och djur. De flesta typer av aspergillus växer på organiskt material, exempelvis jord, döda blad, mat och djurfoder.
Aspergillus förekommer vanligt i inomhusmiljöer, särskilt i fuktiga och dåligt ventilerade utrymmen så som källare, badrum och andra områden med hög luftfuktighet. Exponering till aspergillus kan leda till allergiska reaktioner och sjukdomar som lunginfektioner och astma.
En av de mest kända arterna i Aspergillus släktet är Aspergillus flavus, som är känd för att producera giftiga kemikalier som kallas aflatoxiner. Aflatoxiner är cancerframkallande och kan orsaka allvarliga hälsoproblem hos människor och djur om de konsumeras genom mat eller inandning.
Fusarium: Fusarium är en stor släkt av svampar som finns över hela världen. Det finns cirka 300 olika arter och vissa av dem orsakar sjukdommar för växter, djur och människor. Fusarium-svampar kan också orsaka ruttnande på livsmedel.
Fusarium kan orsaka sjukdomar hos både människor och djur exempelvis hudinfektioner, luftvägsinfektioner och matsmältningsproblem. En av de mest allvarliga sjukdomarna är aspergillos, som främst drabbar personer med nedsatt immunförsvar. Fusarium-svampar trivs i fuktiga och varma miljöer.
Cladosporium: Cladosporium är en stor grupp av mögelsvampar som finns över hela världen och trivs i både inomhus- och utomhusmiljöer. Dessa mögelsvampar förekommer i i luften och kan hittas på en mängd olika ytor.
Cladosporium har ett karakteristisk utseende med mörkbruna eller svarta fläckar som bildar kluster på ytorna där de växer. De producerar sporer som sprids i luften.
Vissa arter av Cladosporium kan orsaka hälsoproblem hos människor. Speciellt bland de med nedsatt immunförsvar. Dessa hälsoproblem inkluderar allergiska reaktioner, såsom rinnande näsa, klåda och astma, samt infektioner i huden och naglarna.
För att minska risken för Cladosporium är det viktigt att hålla miljön torr och ren, särskilt i fuktiga områden som badrum och källare. Det är också viktigt att regelbundet rengöra ytor samt ventilera bostaden för att minska fuktnivåerna och luftföroreningar.

Så bildas svartmögel
Svartmögel frodas i fuktiga miljöer såsom källare, vindsutrymmen och våtutrymmen. Därför upptäcks ofta svartmögel i badrum, kök, källare och vinden. Beroende på hur hög luftfuktigheten är i ditt hem kan svartmögel även uppstå på tapeter, fasader, fönster och väggar.
Oftast förekommer svartmögel vid fuktskador eller i utrymmen med särskilda tempratur- och ljusförhållanden som är svåra att undersöka. Bland annat avlopp, tvättmaskin eller diskbänkar.
Så vet man om man har mögel
Ibland kan det vara svårt att vara säker på om man har eller inte har mögel hemma. Det beror på bland annat att mögelangrepp kan både vara synliga och dolda.
Mögel kan ofta vara små bruna, gröna, gula, vita eller svarta fläckar på ytor. För att säkerställa att du har mögel hemma kan du beställa ett gör-det-själv-test på vår hemsida.
Det finns många olika mögeltester på marknaden som snabbt och enkel ger dig svar på om du har mögel i din bostad.
Om du ser tecken på mögel med blotta ögat är ett yt-test där du “topsar” området att rekomendera. Om du iställer känner symptom av mögel så är ett med avancerat lufttest eller en DNA-analys att rekomendera. De typer av test kan även ge dig svar på vad för mögelsort det är samt hur omfattande omgreppet är.

Så vet man om man har svartmögel
Svartmögel känns igen på sin mörka färg. För att vara helt säker på att korrekt typ av mögel har identifierats är det viktigt att genomföra ett mögeltest innan man behandlar området.
Ett test ger dig svar på vilken typ av mögel som finns i området samt hur allvarligt angreppet är. Ett svartmögeltest är den bästa metoden för att upptäcka ett dolt eller syligt angrepp.
Genom ett mögeltest kan du även upptäcka svartmögel i tid och undvika hälsoriskerna samt skadorna på ditt hem.
Så luktar svartmögel
En annan komplementerande metod för att upptäcka svartmögel är genom lukt. Mögel har en rätt distinkt lukt, oftast beskrivs den som unken eller lik en gammal källare och stuga.
Lukten kan variera mellan en frän lukt till en lätt irriterande unken lukt och även ibland en stickande lukt som orsakar milda besvär. Det är vanligt att mögellukten sätter sig på kläder och får många att känna obehag.
Ofta sätter sig mögeldoften på kläder när de finns mögel i eller kring tvättmaskinen.
Läs ett mer detaljerat inlägg om hur mögel luktar.

Mäta svartmögel själv
Det finns inga problem med att mäta efter mögel själv, att anlita en dyr firma för ett hembesök är inte nödvändigt. Det kan dock vara en bra idé att ta hjälp att analysera resultaten från ditt mögeltest.
På vår hemsida kan du välja det tester som passar din situation bäst och välj om du vill analysera resultatet själv eller ta hjälp av oss. Efter du valt ut ditt test får du de levererat så du kan utföra testet.
Alla våra tester kommer med utförliga bruksanvisningar och är enkla att använda.
Så mäter man svartmögel i hus eller lägenhet och i luften
De finns många olika svartmögeltest på marknaden i olika prisklasser. Du kan själv välja om du vill testa på en specifik yta, i luften eller i damm. De mer avancerade testerna kan även mäta dolt mögel.
Att mäta ett angrepp i luften behöver inte vara svårt. Du kan själv testa för mögelsporer i luften genom vårt lufttest.
Vårt lufttest kontrollerar både för dodla och synliga angrepp. Lufttestet kommer i form av en petriskål där eventuella sporer faller ned i till odlingsmedlet.
Läs ett detaljerat inlägg om allt man behöver veta om mögel i hus.
Läs ett mer detaljerat inlägg om att mäta mögel i en lägenhet.

Skador på byggnaden orsakade av svartmögel
Svartmögel är inte bara en hälsorisk – det kan också orsaka allvarliga skador på byggnader. När möglet växer på material som trä, gips eller isolering, kan det bryta ner dessa material och försämra byggnadens struktur. Detta kan leda till dyra reparationer och i värsta fall skapa allvarliga säkerhetsproblem.
- Trä som angrips av svartmögel kan bli mjukt och poröst, vilket leder till att bärande väggar och tak förlorar sin styrka.
- Gips och isolering kan ta upp fukt och svälla, vilket gör det svårt att återställa byggnaden till sitt ursprungliga skick utan att byta ut materialet.
- I extrema fall kan svartmögel orsaka så mycket skada att hela väggar eller tak måste rivas för att återställa byggnaden.
Så gör man ett svartmögeltest
Att testa din bostad för svartmögel är väldigt enkelt. Allt du behöver är att följa instruktionerna som vi skickar med i förpackningen tillsammans med ditt mögeltest. Beroende på vad för mögeltest du beställler så varierar hur testet genomförs.
Det finns bland annat möjlighet att testa mögel genom en avtrycksplatta, du kan mäta mögel i luften med vårt lufttest. Det finns även lite billigare varianter där du drar en bomullstopp över de angripna området. Här kan du läsa om mer om våra olika mögeltester.
Så mycket kostar ett mögeltest för svartmögel
Priset på svartmögeltester kan variera från runt hundralappen till ungefär 3000 kr. Under varje test på vår sida hittar du information om testets pris. Dessutom erbjuder vi alltid fri frakt.
Billigare mögeltester ger dig oftast ett snabbt svar om du antingen har eller inte har mögel. Mer professionella tester ger dig svar på vilken typ av mögelsvamp du har samt hur allvarligt angreppet är.

Förebyggande åtgärder för att hålla svartmögel borta
Svartmögel trivs i fuktiga och dåligt ventilerade utrymmen. För att förhindra att svartmögel får fäste i ditt hem, är det viktigt att hålla luftfuktigheten under kontroll och säkerställa att byggnaden är väl ventilerad. Här är några förebyggande åtgärder:
- Installera avfuktare i källare, badrum och andra fuktiga utrymmen för att hålla luftfuktigheten under 60%.
- Reparera läckage omgående. Vattenläckor från tak, rör eller fönster kan snabbt leda till fuktskador och mögel.
- Ventilera bostaden ordentligt, särskilt i utrymmen som är utsatta för hög luftfuktighet som badrum och kök.
- Täta fönster och dörrar för att undvika kondens och drag i fuktiga utrymmen.
Svartmögel är farligt
Svartmögel är farligt och kan orsaka skador både på dig och ditt hem. Svartmögel kan både fräta och missfärga de ytor de växer på. Du och personer i din närhet kan även bli väldigt sjuka av svartmögel.
Symptomer som kan uppstå är astmatiska besvär samt allergier. I värsta fall kan man även få kroniska lungproblem och cancer. Därför bör svartmögel identifieras snabbt för att sedan saneras. Försiktighetsåtgärder under saneringen bör även tas.
Om du är gravid bör du undvika svartmögel till högsta grad, både för din och fostrets hälsa.

Symptom man kan få av mögel
Det finns många skrönor och sanningar om vilka symptomer som kan uppstå av mögel. Hur farligt är mögel egentligen? Mögel friger mikroskopiska partiklar som är giftiga. De partiklar kan i fall skapa hälsoproblem.
Symptomer som trötthet, huvudvärk och andra allergiliknande symptomer är vanliga bieffekter. För den som andats in mögen kan mer farliga symptomer uppstå så som kroniska sjukdomar och i extrema fall cancer.
Dessa bieffekter kan både uppstå hos människor och djur. Därför går de inte att betona hur viktigt det är att testa för mögel hemma.
Läs ett mer detaljerat inlägg om symptomer på svartmögel.
Vad händer om man äter mögel?
En vanlig fråga är vad som händer om man äter mögel. Först är det viktigt att skilja på olika typer av mögel och inte oroa sig för den typen av mögel som exempelvis finns i mögelost. Däremot ska mat som varit i närheten av mögel i kylskåpet inte förtäras utan slängas.
Om du mot förmodan skulle förtära mögel så behöver du inte vara orolig. I Sverige är det väldigt ovanligt att maten innehåller så höga halter mögelgifter att du skulle bli akut sjuk. Så länge du har ett bra immunförsvar så kommer kroppen att ta hand om möglet snabbt och förhindra alla negativa effekter.









